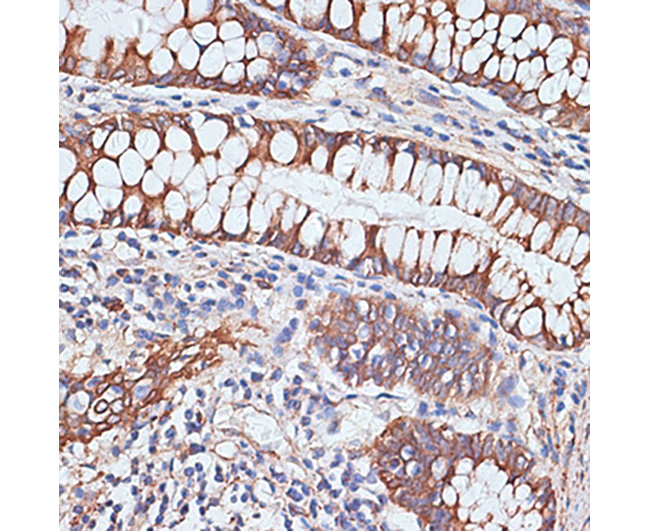
PIGR Rabbit Polyclonal Antibod

相关产品推荐更多 >
万千商家帮你免费找货
0 人在求购买到急需产品
- 详细信息
- 文献和实验
- 技术资料
- 供应商:
上海信裕生物科技有限公司
- 库存:
50
- 克隆性:
多克隆
- 抗原来源:
Rabbit
- 保质期:
一年
- 抗体英文名:
PIGR Rabbit Polyclonal Antibody
- 抗体名:
PIGR Rabbit Polyclonal Antibody
- 保存条件:
PIGR Rabbit Polyclonal Antibody -20ºC保存,Western一抗稀释液-20ºC或4ºC保存,一年有效。Western一抗稀释液优先推荐4ºC保存,长期不使用可以考虑-20ºC保存,但冻融可能会导致出现轻微的浑浊和少量不溶物。
WB, Western blot; IP, Immunoprecipitation; IF, Immunofluorescence; IHC, Immunohistochemistry; ICC, Immunocytochemistry; FC, Flow Cytometry; ChIP, Chromatin Immunoprecipitation Assay; ChIP-seq, ChIP-sequencing.
H, Human; M, Mouse; R, Rat; C, Chicken; Cw, Cow; Dg, Dog; Gp, Guinea pig; Hm, Hamster; Hr, Horse; Mk, Monkey; Pg, Pig; Rb, Rabbit; S, Sheep; Z, Zebrafish; All, all species expected.
配套提供了Western一抗稀释液,可以用于Western检测或其它适当用途时的一抗稀释。
建议抗体使用时的稀释比例如下(实际使用时需根据抗原水平的高低作适当调整):
| WB | IP | IF | IHC | ICC | FC | ChIP | ChIP-seq |
| 1:500-1:2000 | - | 1:50-1:200 | 1:50-1:200 | 1:50-1:200 | - | - | - |
抗体详细信息如下::
| About this Antibody | |
| Name | PIGR Rabbit Polyclonal Antibody |
| Category | Rabbit Polyclonal Antibody (pAb); Primary antibody |
| Isotype | IgG |
| Purification method | Affinity purification |
| Positive samples | HT-29, LO2, 293T, A-549, SGC-7901, Mouse liver, Rat intestine, Rat liver |
| Cellular location | Cell membrane, Secreted, Single-pass type I membrane protein |
| Customer validation | - |
| About the Immunogen | |
| Immunogen | Recombinant fusion protein of human PIGR (NP_002635.2). |
| Sequence | ARARHRKNVDRVSIRSYRTDISMSDFENSREFGANDNMGASSITQETSLGGKEEFVATTESTTETKEPKKAKRSSKEEAEMAYKDFLLQSSTVAAEAQDGPQEA |
| Gene ID | 5284 |
| Swiss Prot | P01833 |
| Synonyms | PIGR; polymeric immunoglobulin receptor |
| Category | TGF-β Signaling; MAPK/Erk in Growth & Differentiation; Toll-Like Receptor Signaling |
| Background | This gene is a member of the immunoglobulin superfamily. The encoded poly-Ig receptor binds polymeric immunoglobulin molecules at the basolateral surface of epithelial cells; the complex is then transported across the cell to be secreted at the apical surface. A significant association was found between immunoglobulin A nephropathy and several SNPs in this gene. |
包装清单:
| 产品编号 | 产品名称 | 包装 |
| XY-7746 | PIGR Rabbit Polyclonal Antibody | 50μl |
| XY-050 | Western一抗稀释液 | 50ml |
| — | 说明书 | 1份 |
保存条件:
PIGR Rabbit Polyclonal Antibody -20ºC保存,Western一抗稀释液-20ºC或4ºC保存,一年有效。Western一抗稀释液优先推荐4ºC保存,长期不使用可以考虑-20ºC保存,但冻融可能会导致出现轻微的浑浊和少量不溶物。
注意事项:
如果本抗体用于Western blot (WB)、免疫荧光(IF)、免疫细胞化学(ICC)等实验,请注意回收使用过的稀释抗体。回收的抗体通常至少可以重复使用5-10次。稀释后的抗体,包括已经使用过的稀释抗体,请4℃保存。
回收后重复使用的抗体,使用方法同新鲜稀释的抗体。如果在重复使用过程中发现抗体出现轻微混浊现象,可以10,000g离心1-3分钟,取上清用于后续检测。如果回收的抗体出现明显的絮状物或长霉长菌等情况,则可以考虑废弃该抗体。
提供的Western一抗稀释液也可以用于免疫荧光(IF)、免疫组化(IHC)、免疫细胞化学(ICC)等适当用途。如果希望获得最佳的检测效果,请考虑使用上述检测专用的一抗稀释液。
本产品仅限于专业人员的科学研究用,不得用于临床诊断或治疗,不得用于食品或药品,不得存放于普通住宅内。
为了您的安全和健康,请穿实验服并戴一次性手套操作。
使用说明:
请根据抗体的实际用途选择相应的使用方法。
1. Western检测:
a. 按照推荐的稀释比例用信裕生物提供的Western一抗稀释液稀释抗体。
b. 把经过封闭的蛋白膜与稀释好的一抗4℃缓慢摇动过夜或室温缓慢摇动2小时,确保稀释的抗体至少能在摇动的瞬间覆盖蛋白膜。
c. 回收稀释的一抗,4℃保存以备下次继续使用。
d. 按照Western的实验步骤进行后续的洗涤、二抗孵育、洗涤和检测等操作。
2. 免疫染色:
可以使用信裕生物生产的免疫染色一抗稀释液(P0103)稀释抗体,使用后注意回收稀释好的一抗,
3. 其它实验操作请自行参考适当的protocol进行。
4. 代表性图片:
![]() |
![]() |
| Fig. 1. Western blot analysis of extracts of various cell lines, using PIGR antibody at 1:1000 dilution. Secondary antibody: HRP-labeled Goat Anti-Rabbit IgG(H+L) (A0208) at 1:1000 dilution. Lysates/proteins: 25µg per lane. Blocking buffer: QuickBlock™ Blocking Buffer (P0231). Detection: BeyoECL Star (P0018A). Exposure time:1s. | Fig. 2. Immunohistochemistry of paraffin-embedded human liver cancer using PIGR antibody at dilution of 1:100 (40x lens). |
![]() |
|
| Fig. 3. Immunohistochemistry of paraffin-embedded human colon using PIGR antibody at dilution of 1:100 (40x lens). | |
风险提示:丁香通仅作为第三方平台,为商家信息发布提供平台空间。用户咨询产品时请注意保护个人信息及财产安全,合理判断,谨慎选购商品,商家和用户对交易行为负责。对于医疗器械类产品,请先查证核实企业经营资质和医疗器械产品注册证情况。
文献和实验Polyclonal Antibody Production
Zealand White Rabbits and have them delivered to the ARC. Don’t put all your eggs in one basket only using one rabbit. Let them get accustomed to there home there for two weeks before the first pre-bleed. Pre-bleed
Polyclonal Antibody Production
Polyclonal Antibody Production Very useful for rapid and simple generation of antibodies for western blots, ELISA assays, and immunoprecipitation. Rabbit Immunization Initial Preparation Your antigen
Generation and Selection of Rabbit Antibody Libraries by Phage Display
The rabbit antibody repertoire is an exceptional source for both polyclonal antibodies (pAbs) and monoclonal antibodies (mAbs) that combine high specificity with high avidity and affinity, respectively. In contrast to rabbit pAbs
技术资料暂无技术资料 索取技术资料